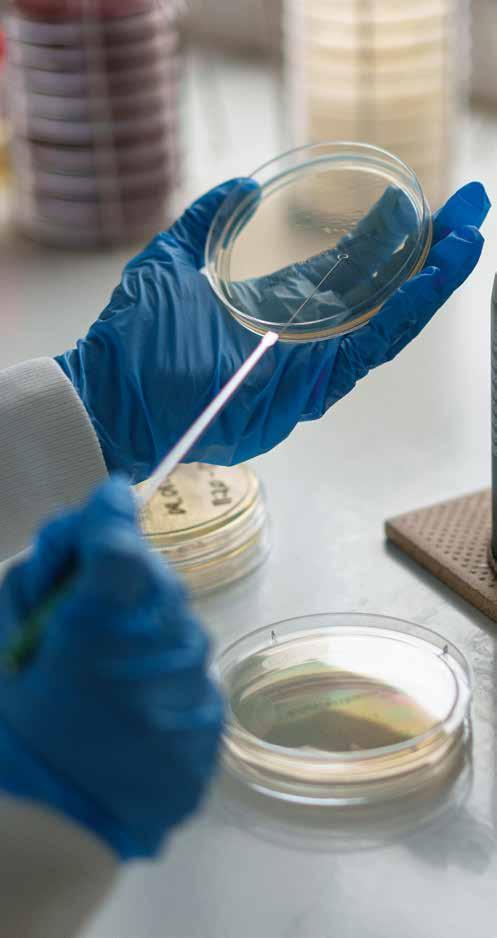

OFFICIAL RACEDAY PROGRAMME £3.00 salisburyracecourse.co.uk Friday 9th September 2022



Equine Welfare & Integrity Officers: Mel Baker, Steve Fox, Stuart Shilston Published by Authority of the Clerk of the Course
ABOVE IMAGE: JULIET SIERRA (pink cap) wins a strong looking renewal of the Dick Poole Group 3 race for 2 year old fillies under Rob Hornby and for local trainer, Ralph OPPOSITEBeckett.
Commentator: Richard Hoiles
IMAGE: : EXIMIOUS is victorious in the valuable 2 year old fillies Maiden Stakes over 7 furlongs.
Betting Ring Manager: Vicki Moore
Starters: William Jordan, Sophia Upton Judge: Emily Jones Clerk of the Scales: Chris Hill
Ambulance Providers: Medicare EMS Group UK Ltd Veterinary Officer: David Freeman Veterinary Surgeons: Mr Martin Peaty B.V.Sc., CertEP., M.R.C.V.S. Mr Scott Milnes, B.V.Sc., CertEP., M.R.C.V.S. & Alistair Lees B.VET.MED., M.R.C.V.S.
PATRON: Michael E. Wates, CBE DIRECTORS OF THE BIBURY CLUB LTD: Lord Margadale (Chairman), The Earl of Huntingdon, Mrs H. G. Clinch, Peter Treadgold, William Norris QC, Jeff Smith, Jeremy Martin (Executive)
FRONT COVER IMAGE: The Sir Michael Stoute trained, and Her Majesty The Queen owned, CIRCLE OF FIRE, ridden by Ryan Moore, is an impressive winner of the 2 year old Novice Stakes over 1 mile on 1st September.

OFFICIALS AND WELCOME
Racecourse Medical Officers: Dr Peter Phillips, Dr Anne Lashford, Dr Heather Clark Nurse: Gloria McNab
CLERK OF THE COURSE: Jeremy Martin Financial Controller: Neil Williams Head Groundsman: Glen Mason Catering Manager: Sylvia Taylor Bars Manager & Head of Safeguarding: Debbie Mouland Chief Steward: Steve Drowne Stewards’ Panel Chair: Charlie Lane Stewards: Milly Bersey, Sophie Candy, Ali Galliers-Pratt, Richard Westropp
& Clerk of the Course STATISTICS LEADING JOCKEYS & TRAINERS AFTER 14 RACE MEETINGS: LEADING JOCKEYS: 5 WINNERS: PAT DOBBS, DAVID EGAN, ANDREA ATZENI 4 WINNERS: JAMES DOYLE, HOLLIE DOYLE, CONNOR PLANAS 3 WINNERS: HECTOR CROUCH, JOSHUA BRYAN, HAYLEY TURNER LEADING TRAINERS: 9 WINNERS: RICHARD HANNON 7 WINNERS: ROGER VARIAN 6 WINNERS: ANDREW BALDING 5 WINNERS: CLIVE COX 4 WINNERS: ARCHIE WATSON, ROD MILLMAN 3 WINNERS: RALPH BECKETT, MILTON HARRIS, EVE JOHNSON-HOUGHTON
WELCOME TO SALISBURY RACECOURSE
Welcome to our September Friday evening race meeting. It features the Weatherbys sponsored Persian Punch Conditions Stakes which has been won in the last two years by stayers that have become ‘top-drawer’ since, with Trueshan in 2020 (current BHA Rating of 124) and Quickthorn (117) in 2021. The rains finally arrived this week and for the first time this season we have racing ground on the soft side. Today is expected to be sunshine and showers, but hopefully it will be less of the latter. Racing this evening is in support of Julia’s House, the Wiltshire and Dorset Children’s Hospices, so please do support with their fundraising effort if you can. Details of how this can be done are found within the racecard. Thank you for coming racing this evening – the Salisbury team hope that you have a very enjoyable visit. Our final race meeting of the season is in just under three weeks’ time on Thursday 29th
ExecutiveJeremyBestSeptember.wishesMartinDirector

The BHA Handicappers allot ratings to horses once they have taken part in a sufficient number of races to enable the Handicappers to make a numerical assessment of each horse’s ability. The principal purpose of the ratings is to determine the weight to be carried by each runner in handicap races, with the Handicappers aiming to provide each participant with an equal chance based on its best recent form under its optimum conditions. A horse rated 100, for example, would be set to carry 1lb more than a horse rated 99 (ignoring any penalties or Theallowances).ratingspublished in the racecard for handicap races are the ratings that were used to calculate the weight to be carried by each horse, whilst in non-handicaps races the rating shown is that of each runner at the time that the entries for the race were confirmed. Any subsequently published change to a rating, either up or down, is shown in brackets following the rating.
Each
1 Colours Graphic - a visual of the Owners Silks that the Jockey will be wearing 2 Horse’s number on saddlecloth 3 Colour and sex of horse: B - Bay c - colt (followed by Sire and Dam) Br - Brown h - horse Ch - Chesnut g - gelding Gr - Grey f - filly Ro - Roan m - mare 4 Horse’s name 5 Country of Origin if not GB 6 Number of day’s since horse last ran 7 Age of horse 8 Weight the horse carries in Stones and Pounds 9 Draw 10 Breeder 11 Jockey’s Name. If there is a number next to the name, this indicates that the jockey can claim amountthatin weight (lbs) off the stated riding weight. 12 Owner’s Name(s) 13 Trainer’s Name and location of training establishment 14 Sponsor 15 Star Rating (see below) 16 Details of horse’s previous performances: Bold type indicates All-Weather Track form / denotes new season - denotes new year C - The horse has won on this racecourse D - The horse has won over this distance CD - The horse has won over both this course and distance BF - The horse was a beaten favourite on its last run 17 A guide to the horse’s recent form
By
Can
OFFICIAL BHA RATING
Unlikely
STAR RATING EXPLAINED horse has been given a star rating, these are defined below: Selected to win the race. Good chance of being placed. no means out of the reckoning but at least one or two hold stronger claims to win but not totally without hope. be given little or no chance.
HOW TO READ THE RACECARD 4 MEGALLAN (GB) (67) 3 8-10 (4) Breeding B f Duke of Marmalade (IRE) - Guantanamera (IRE) Jockey Robert Havlin Owner Mr A. E. Oppenheimer Trainer John & Thady Gosden, Newmarket Breeder Hascombe & Valiant Stud Ltd Timeform Rating Sponsor Tote Form 40-2120 D TIMEFORM Smart colt who followed a Listed success at Newcastle with an excellent second in the Dante at York. Underperformed in the French Derby since but this is more realistic. BHA 110 1 17 3 4 6 2 5 7 8 9 12 10 1311 15 14 16
WIN: EXPEDITIOUS DANGER: LOST ANGEL RACE FOUR
WIN: WHISTLEDOWN DANGER: BRAZEN IDOL RACE FIVE Ranch Hand ended his last season with some creditable efforts in Group and Listed territory and is of interest on his return to action. However, preference is for GLOBAL HEAT, who sports first-time blinkers following a good second over 1m4f at Ripon in July. He is entitled to build on that showing up in trip, while the grade dropping Dillian is another worthy of consideration.
WIN: ALMUTAWAKEL DANGER: THE GOAT RACE TWO SURELY NOT made a pleasing start in nurseries when third in a hot race at Goodwood in July and off just 1lb higher, he'll be tough to beat in this company. Day Member looked ready for this stiffer test when fifth at Wolverhampton nine days ago and she should go well, while Caernarfon looks nicely treated off a mark of 70 on some of her form in novice events.
WIN: SURELY NOT DANGER: DAY MEMBER RACE THREE EXPEDITIOUS had excuses when putting in a below par performance at Goodwood on Tuesday and, if turned out quickly here, she could make amends off bottom-weight. Clive Cox's filly Lost Angel looks to be the biggest danger despite disappointing at Windsor last week, while Puffable would have every chance if bouncing back to the form of her nursery win at Brighton in July.
TODAY’S TIPS RACE ONE A few promising types here, but ALMUTAWAKEL is given another chance after disappointing at Epsom last time. Owen Burrows' son of Acclamation made a pleasing start at Ffos Las when second and he's fancied to confirm that promise and get off the mark here. Bussento has shown plenty of promise in his first couple of starts and he's not ruled out, but The Goat is most interesting of the rest after he caught the eye when third on debut at Nottingham last month.
WHISTLEDOWN has filled the runner-up spot on her last three outings and a drop in trip could be what she needs to make a return to the winner's enclosure. Mick Channon's filly retains the mark from her latest run at Epsom, where she was just denied by a neck over 7f, and she looks set to improve on that. Hat-trick seeking Brazen Idol seems her biggest threat, while Juanita is another to note.
WIN: REGAL RAMBLER DANGER: NOBEL
Nobel made a pleasing start to his racing career when recording an eye-catching win over 1m last December at Kempton and he warrants respect back from a break, but REGAL RAMBLER built on his racecourse bow when finishing a good second over 1m at Chelmsford on his latest outing and gets the nod. That latest run gave the impression that a stiffer stamina test should suit, while Firth Of Clyde is another not to be dismissed on his return.
WIN: GLOBAL HEAT DANGER: RANCH HAND RACE SIX
› Monthly Auctions › Valuations for Sale or Probate › Free Local Home Visits › Full or Part House Clearance NOW ACCEPTING ENTRIES Antiques, Collectibles, Furniture, Gold, Silver and Jewellery, Oriental and Islamic Items, Fine Art, Ceramics and Glass, Militaria, Rugs, Garden Items, Classic Vehicles and Automobilia Clarke’s Auctions Units 1 & 2 Kingsettle Business Park, Station Road, Semley, Shaftesbury SP7 9BU Telephone: 01747 www.clarkesauctions.co.ukenquiries@clarkesauctions.co.uk855109 Clarke’s Auctions Auctioneers & Valuers

Nucleus, Dunn’s House, Salisbury SP2 7BF Have a great day. Nucleus Financial Platforms group is an entity of Nucleus Financial Ltd (05522098) a company registered in England, United Kingdom with the registered address Dunn’s House, St Paul’s Road, Salisbury SP2 7BF.
As one of Salisbury’s largest employers, we’re delighted to be supporting Julia’s House charity and today’s racing.
www.nucleusfinancialplatforms.com

TIMEFORM Foaled March 6. 22,000 gns yearling, Australia colt. Closely related to useful winner up to 7.4f Evocative Spark. Newcomer can’t be ruled out. BHA7 BUSSENTO (GB) (28) (2lb) 9-5 (5) Breeding B c Oasis Dream - Super Saturday (IRE) (Pivotal) Jockey Charles Bishop Owner Mick and Janice Mariscotti Trainer Eve Johnson Houghton, Blewbury Breeder Glebe Farm Stud Timeform Rating HHHHI Sponsor Abm Catering Limited Form 43
Trainer-in-form (last 14 days): A Balding (6 wins from 52 runners, 12%) runs THE GOAT Longest Traveller: AUSSIE MYSTIC trained by C Fellowes, Newmarket, 151 miles.
TIMEFORM Promising individual. 7/4, fourth of 8 in minor event at Epsom (7f, good to firm) 43 days ago. Should have more to offer. BHA6 AUSSIE MYSTIC (GB) (-) (2lb) 9-5 (2) Breeding B c Australia - Hyper Dream (IRE) (Oasis Dream) Jockey Stevie Donohoe Owner Dahab Racing Trainer Charlie Fellowes, Newmarket Breeder V. I. Araci Timeform Rating HHHII Form
TIMEFORM Promising type. Third of 12 in maiden at Newbury (7f, good to firm, 11/4) 28 days ago. May well do better. In the mix. BHALeading course trainer (17-22): R Hannon (31 wins from 331 runners, 9%) runs LAVENDER BEAUTY
RACE STATISTICS PLAY SMARTER 8 FIRST RACE 4.50PM 1mTHE NUCLEUS FINANCIAL SUPPORTING JULIA’S HOUSE RESTRICTED NOVICE STAKES (CLASS 4) (for horses in Bands B, C and D) (GBB RACE) for novice two yrs old x Total race value £9000 x Race Conditions P31 Owners Prize Money. 1st £3840, 2nd £1920, 3rd £960, 4th £480. (Penalty Value £4860) Weights raised 3lb and paragraphs 27 to 31 of the Weights and Handicapping Code complied with where applicable. 1-2-3: 1.STAR (FR) 2.BUSSENTO 3.ALMUTAWAKEL colours no horse/days since last run st-lb Draw 1 ITHACA’S ARROW (GB) (-) 9-7 (7) Breeding Ch c Ulysses (IRE) - Eyeshine (Dubawi (IRE)) Jockey Liam Keniry Owner The Agincourt Partnership Trainer Dominic Ffrench Davis, Lambourn Breeder W. Farish Snr & Flaxman Stables Ireland Timeform Rating HHIII Sponsor The Cherwell Group Form TIMEFORM Foaled April 16. 35,000 gns yearling, Ulysses colt. Half-brother to 12.5f winner Maloja. Others appeal more. BHA2 STAR (FR) (-) 9-7 (1) Breeding B c Cloth of Stars (IRE) - Municiadora (BRZ) (First American (USA)) Jockey Hector Crouch Owner Hambleton Racing Ltd XVIII & Partner Trainer Archie Watson, Upper Lambourn Breeder E.A.R.L Haras Du Logis Et al Timeform Rating HHHHH Sponsor Hambleton Racing Ltd Form TIMEFORM Foaled February 26. €40,000 yearling, Cloth of Stars colt. Half-brother to several winners, including smart 1m winner Braco Forte and 1 1/4m winner Gold. Dam unraced. One to take seriously on debut. BHA3 THE GOAT (GB) (31) 9-7 (4) Breeding Ch c Cracksman - My Hope (USA) (Afleet Alex (USA)) Jockey Joshua Bryan Owner THE TRUE ACRE PARTNERSHIP 1 Trainer Andrew Balding, Kingsclere Breeder Cheveley Park Stud Limited Timeform Rating HHHII Sponsor Tote Form 3 TIMEFORM 4/1, third of 8 in maiden at Nottingham (8.3f, good to firm) on debut 31 days ago. Open to improvement. Considered. BHA4 YOUM ZAMAN (IRE) (14) 9-7 (8) Breeding B c Kodiac - Arty Crafty (USA) (Arch (USA)) Jockey Thomas Greatrex Owner Mr Jaber Abdullah Trainer Harry & Roger Charlton, Beckhampton Breeder Airlie Stud Timeform Rating HHHII Form 05
TIMEFORM Twice-raced maiden. 18/1, fifth of 13 in minor event at Ffos Las (7.4f, good) 14 days ago. More is required. BHA5 ALMUTAWAKEL (GB) (43) (2lb) 9-5 (3) Breeding B g Acclamation - Inpromptu (IRE) (Cacique (IRE)) Jockey Tom Marquand Owner Ahmad Al Shaikh Trainer Owen Burrows, Lambourn Breeder Carisbrooke Stud Timeform Rating HHHII Form 24 BF

RACEFIRST 9
Breeding B f Le Havre (IRE) - Onceuponastar (IRE) (Sea The Stars (IRE)) Jockey Sean Levey Owner Sheikh Hamed Dalmook Al Maktoum Trainer Richard Hannon, Marlborough Breeder Plantation Stud Timeform Rating HHHII Form 33
Race Summary: STAR is bred to be useful so is taken to make a winning start for Archie Watson at the chief expense of Bussento, who just holds the edge of those with experience. Almutawakel and The Goat both look open to improvement too though so also need factoring in. FREE form for all British and Irish meetings is available online every day at timeform.com/free
8 LAVENDER BEAUTY (IRE) (13) 9-2 (6)

TIMEFORM Twice-raced maiden. 7/2, third of 8 in minor event at Goodwood (6f, good) 13 days ago. Significantly up in trip. Should progress. BHADECLARED RUNNERS 8 2021: JACK DARCY (IRE) 2 9 0 Cieren Fallon 11-1 (Paul & Oliver Cole) 9 ran Raceform Median Time: 1 min 43.50 secs Betting Forecast: 13-8 Bussento (GB), 5-1 Almutawakel (GB), 13-2 The Goat (GB), 7-1 Lavender Beauty (IRE), 9-1 Star (FR), 16-1 Aussie Mystic (GB), 20-1 Youm Zaman (IRE), 40-1 Ithaca’s Arrow (GB)
PLAY SMARTER 1ST 2ND 3RD 4TH GREAT BRITISH BONUS SCHEME The Great British Bonus (GBB) offers multiple bonuses of up to £20,000 per eligible race for British-bred fillies and mares. POSITION OF STALLS 6F, 7F & 1M - FAR SIDE 1M2F - INSIDE HBLB The Horserace Betting Levy Board General Prize Fund scheme provides for the inclusion of £545,374 at this Racecourse in 2022.


SPONSORS THANK YOU The Directors and Sta would like to thank our sponsors today for kindly supporting the racecourse and by contributing to prize money. The family of Archie Ford SymondsCateringEvent ® Family run food production using fresh, good quality products, with nothing but the best ingredients! • Fresh sandwiches • baguettes • salads • andpanini’s……muchmore Delivered daily to customers in Andover, Salisbury, Bournemouth, Portsmouth and London. 01264 848 202www.tuckboxfresh.co.ukorders@tbfresh.co.uk






justpossibilitiesofwaitingtobeexplored.
Proud to Support all blessed with One Life, but within it there is literally a world


Julia’s House
We’re
It’s our mission here at Imagine Cruising to help you discover this incredible planet, to inspire you and help you experience as many unforgettable moments as possible. We strive to take you beyond your cruising dreams and constantly search for new travel experiences that will exceed your expectations. We put a great deal of time and care into tailoring cruise holidays to suit every kind of traveller and that offer you incredible value. Explore charming cosmopolitan cities, escape to idyllic beaches and seek out the world’s greatest wonders, all in one holiday. Resulting in the creation of luxury cruising experiences that are so much more than you can imagine. imaginecruising.co.ukTOFINDOUTMOREVISITORCALL01793547447
ABTA No.Y6300 11078 OPENING HOURS: MON - SUN 9AM - 8PM

RACE STATISTICS PLAY SMARTER 12 SECOND RACE 5.20PM 6f 213yTHE IMAGINE CRUISING SUPPORTING JULIA’S HOUSE NURSERY HANDICAP STAKES (CLASS 5) for two yrs old x Total race value £8500 x Race Conditions P31 Owners Prize Money. 1st £3371, 2nd £1685, 3rd £843, 4th £421, 5th £240, 6th £240. (Penalty Value £4266) 1-2-3: 1.SURELY NOT (IRE) 2.DAY MEMBER 3.CAERNARFON colours no horse/days since last run st-lb Draw 1 SURELY NOT (IRE) (43) 9-9 (6) Breeding B c National Defense - Thanks (IRE) (Kheleyf (USA)) Jockey Joshua Bryan Owner The Agincourt Partnership and Other Trainer Dominic Ffrench Davis, Lambourn Breeder Mrs E. Thompson Timeform Rating HHHHH Sponsor The Cherwell Group Form 0103 D TIMEFORM Winner at Lingfield in June. Good third of 12 in nursery (28/1) at Goodwood (7f, good to firm) 43 days ago, finishing best. Big player. BHA 75 2 DOUBLE O (IRE) (29) 9-8 (4) Breeding B f Kessaar (IRE) - Calorie (Sea The Stars (IRE)) Jockey Cieren Fallon Owner Amo Racing Limited Trainer David Loughnane, Tern Hill Breeder Paul & Billy McEnery Timeform Rating HHHII Sponsor Sports Invest UK Ltd Form 231024 TIMEFORM Winner at Pontefract in June. 6/1, respectable fourth of 8 in nursery at Lingfield (7f, AW) 29 days ago. Can give a good account. BHA 74 3 HAUGHTY (GB) (27) 9-5 (1) Breeding B f Adaay (IRE) - So Hoity Toity (Harbour Watch (IRE)) Jockey Martin Harley Owner Mr Robin Mathew Trainer Alan King, Barbury Castle Breeder Robin Mathew Timeform Rating HHHII Sponsor Goodwin Racing Ltd Form 0223 TIMEFORM Lightly-raced maiden. 7/1, last of 3 on nursery bow at Doncaster (8f, firm) 27 days ago. BHA 71 4 CAERNARFON (GB) (15) 9-4 (5) Breeding B f Cityscape - Royal Ffanci (Royal Applause) Jockey George Bass (3) Owner Hunscote Stud Limited Trainer Mick Channon, West Ilsley Breeder Hunscote Stud Timeform Rating HHHII Sponsor Mike Channon Bloodstock Ltd Form 4322 TIMEFORM Lightly-raced maiden. 13/2, creditable second of 9 in novice event at Chelmsford City (7f) 15 days ago, no match for winner. Makes handicap debut. Respected. BHA 70 5 DREAM OF MISCHIEF (GB) (14) 9-4 (2) Breeding B c Oasis Dream - Saucy Minx (IRE) (Dylan Thomas (IRE)) Jockey Sean Levey Owner Mrs F Cotton,Mr & Mrs P Conway Trainer Amanda Perrett, Pulborough Breeder Mr & Mrs Cotton / Mrs Suzanne Conway Timeform Rating HHHII Sponsor Tote Form 005 TIMEFORM Thrice-raced maiden. 80/1, fifth of 7 in novice event at Newmarket (7f, good to soft) 14 days ago. Makes handicap debut. BHA 70 6 DAY MEMBER (GB) (9) 9-4 (3) Breeding B f Twilight Son - Clubbable (Mayson) Jockey Tom Marquand Owner Cheveley Park Stud Trainer William Haggas, Newmarket Breeder Cheveley Park Stud Limited Timeform Rating HHHHI Sponsor Cheveley Park Stud Form 6535 TIMEFORM Looked to have been handed a lenient opening mark but wasn’t seen to best effect switched to nurseries when fifth of 10 at Wolverhampton (6.1f, 7/2) 9 days ago. Worth another chance. BHA 70 (-2) 7 RICARDO OFWORTHING (IRE) (20) 9-0 (7) Breeding B c Dandy Man (IRE) - Shamardyh (IRE) (Shamardal (USA)) Jockey Paddy Bradley (3) Owner Miss S. Groves Trainer Jim Boyle, Epsom Breeder Mr Dermot Cogan Timeform Rating HHIII Form 003 TIMEFORM Thrice-raced maiden. 100/1, third of 9 in novice event at Lingfield (6f, AW) 20 days ago, having run of race. Makes handicap debut. Plenty more needed. BHA 66 (-2) Leading course trainer (17-22): M Channon (14 wins from 108 runners, 13%) runs CAERNARFON Trainer-in-form (last 14 days): W Haggas (8 wins from 45 runners, 18%) runs DAY MEMBER Longest Traveller: DOUBLE O trained by D Loughnane, Tern Hill, 163 miles. ®
NATIONAL ASSOCIATION OF BOOKMAKERS
DECLARED RUNNERS 7 2021: MY LITTLE TIP (IRE) 2 8 8 Aled Beech 2-1 (George Boughey) 10 ran Raceform Median Time: 1 min 30.50 secs Sheepskin Cheek Pieces worn by No. 6. Stewards Note: SURELY NOT: Following its run on 28/7/2022 it was reported that the horse ran freely and hung right handed. Betting Forecast: 2-1 Surely Not (IRE), 4-1 Day Member (GB), 11-2 Caernarfon (GB), 6-1 Double O (IRE), 12-1 Haughty (GB), Dream of Mischief (GB), 22-1 Ricardo Ofworthing (IRE)
RACESECOND 13
ABANDONMENT
FREE form for all British and Irish meetings is available online every day at timeform.com/free

REFUND
Race Summary: SURELY NOT was arguably unlucky not to make a winning nursery bow when just failing at Glorious Goodwood 6 weeks ago and can make amends off a similar mark. Day Member rates the main threat having not been seen to best effect on nursery debut at Wolverhampton, with Caernarfon best of the others.
PLAY SMARTER 1ST 2ND 3RD 4TH THANKS TO Hendy Jaguar Southampton, Hendy Land Rover Salisbury, Hendy ŠKODA Salisbury and Lexus Poole for supporting Salisbury

In the event of Abandonment of Racing prior to the first race, a full refund will be made to racegoers whom have paid for daily admission. If racing is abandoned after the first race has been run and before the third race has been run, a 50% refund will be made. After the third race has been run, no refunds will be made. Applications must be made in writing to the Racecourse Office within 14 days of the race meeting and must be accompanied by the daily admission badge or Course Enclosure pass out. No refunds will be made in the race day.
Bookmakers, both on and off the course are helping to pay for the improvement of racing through the Levy Fund.
Racecourse.hendy.co.uk

All time high! From 5f to 15f, the British EBF aims to allocate £1.7million contributed by GB based stallion studs to flat racing’s prize money in 2022. SECARTALFHSITIRB AH V E BENEFITTEDFROM IMPROVEDPRIZEMONEY FR O M FBE SNOITUBIRTNOC OVER 700 FLAT RACES £100 ,000 IF N A L S | EBF OTDETUBIRTNOC RB I T I S H RACINGSINCE1983 | CONTRIBUTEDTO BR I T I S H NICARGECNIS1|389 £36 MILLION+ #GoodForRacing T: +44 1638 667960 E: info@ebfhorseracing.co.uk @BritishEBF www.ebfstallions.com







Archie was named after the racehorse ‘Archie Babe’ trained by John Quinn. He was just 7 days old when he went to his first race meeting at Salisbury Racecourse on Tuesday 14th September 2004 and has been going regularly every year since, with parents Dave & Sue, who have been annual badgeholders since 2002.
Tonight,
HappyBirthday18thArchie!xxxxxxx Irish 18thARCHIEFarmsStallionEBF/FORDBIRTHDAYFillies’NurseryHandicap

Archie was home schooled, meaning he never had to miss a race meeting, and these were some of his best maths lessons! Archie is celebrating his 18th Birthday at the racecourse with his Mum, Dad, sister Amy, Grandad Dan and some of his friends. He is looking forward to having his first bet and beer at the course.

DECLARED RUNNERS 4 2021: AMBER DEW 2 8 13 Hector Crouch 13-2 (Ralph Beckett) 5 ran Raceform Median Time: 1 min 16.50 secs Stewards PUFFABLENote: : Following its run on 21/7/2022 it was reported that the horse ran too soon after its last trip. Betting Forecast: 13-8 Lost Angel (IRE), 7-2 Puffable (GB), Expeditious (GB), 4-1 Hoof It Hoof It (IRE)
HOOF IT Trainer-in-form
PLAY SMARTER 1ST
TIMEFORM Lightly-raced winner. Winner at Newbury in August. 16/1, 14 1/4 lengths last of 6 to Shouldvebeenaring in listed race at Ripon (6f, good to firm) 11 days ago. Makes handicap debut. BHA 81 (-1) 3 PUFFABLE (GB) (50) 8-12 (4) Breeding B f Kodiac - Puff (IRE) (Camacho) Jockey Hector Crouch Owner Mr and Mrs David Aykroyd Trainer Ralph Beckett, Kimpton Down Breeder Beaslay Thoroughbreds Timeform Rating HHHHI Sponsor R M Beckett Ltd Form 64315 BF TIMEFORM Lightly-raced winner. Winner at Brighton in July. 9/4, fifth of 6 in nursery at Newbury (6f, good to firm) 50 days ago. Can go well after a break. BHA 73 4 EXPEDITIOUS (GB) (3) 8-10 (3) Breeding B f Fast Company (IRE) - Voladora (IRE) (Medaglia d’Oro (USA)) Jockey Kieran O’Neill
RACE STATISTICS PLAY SMARTER 17 THIRD RACE 5.50PM 6fTHE IRISH STALLION FARMS EBF ARCHIE FORD 18TH BIRTHDAY FILLIES’ NURSERY HANDICAP STAKES (CLASS 3) for two yrs old fillies x Total race value £15000 x Race Conditions P31 Owners Prize Money. 1st £6401, 2nd £3200, 3rd £1601, 4th £800. (Penalty Value £8100) Weights raised 6lb and paragraphs 27 to 31 of the Weights and Handicapping Code complied with where applicable. 1-2-3: 1.LOST ANGEL (IRE) 2.PUFFABLE 3.EXPEDITIOUS colours no horse/days since last run st-lb Draw 1 LOST ANGEL (IRE) (8) 9-9 (1) Breeding Gr f Dark Angel (IRE) - Last Bid (Vital Equine (IRE)) Jockey Tom Marquand Owner Atlantic Equine Trainer Clive Cox, Hungerford Breeder Grangemore Stud Timeform Rating HHHHH Sponsor Clive Cox Racing Limited Form 100635 TIMEFORM Winner at Nottingham in April. 3/1, not clear run when fifth of 9 in nursery at Windsor (5.1f, good to firm) 8 days ago, running on. Worth another chance to confirm the form of her York run. BHA 84 2 HOOF IT HOOF IT (IRE) (11) 9-6 (2) Breeding B f Prince of Lir (IRE) - So Devoted (IRE) (Holy Roman Emperor (IRE)) Jockey Sean Levey Owner Middleham Park Racing LIV Trainer Richard Hannon, Marlborough Breeder Patrick F. Kelly Timeform Rating HHHII Sponsor Tattersalls (Ireland) Ltd Form U0516 D
3RD
Race Summary: LOST ANGEL is better judged on her improved York run having not been seen to best effect at Windsor last week and this looks a good opportunity for her. Puffable might have found her last run coming too soon having made a winning nursery debut at Brighton the previous week so is feared most back from a break. FREE form for all British and Irish meetings is available online every day at timeform.com/free 2ND 4TH course trainer (17-22): R Hannon (31 wins from 331 runners, 9%) runs HOOF IT (last 14 days): C Cox (6 wins from 39 runners, 15%) runs LOST ANGEL Traveller: EXPEDITIOUS trained by A Haynes, Newmarket, 151 miles.
Owner G. Firmager Trainer Alice Haynes, Newmarket Breeder Godolphin Timeform Rating HHHII Sponsor Colourpin Form 662414 D BF TIMEFORM Winner at Chelmsford City in August. Fourth of 5 in nursery (9/4) at Goodwood (6f, good to soft) 3 days ago. BHA 71
RACETHIRD Leading
Longest
THE FAMILY OF ARCHIE FORD
CASH MACHINE A cash machine can be found in the passage way outside the Racecourse Office (for Bibury Enclosure and Grandstand & Paddock Enclosure customers). A charge of £2 per transaction is made. This cash machine only has cash available on racedays.
WILL BELEGACYYOURELLIE’S Registered Charity No. 1067125 Julia’s House provides a lifeline of care for seriously ill children across Wiltshire. Incredibly, 1 in 4 of the children we care for are supported by Gifts in Wills. Even a gift of just 1% could make 100% difference to families like Ellie’s. Your lasting gift of care will never be forgotten. Visit juliashouse.org/legacy or call 01202 644220 Leave a Gift in your Will with our free Will writing service













Medical Wire & Equipment Co. (Bath) Ltd Corsham, Wiltshire, England, SN13 9RT +44 (0)1225 810361 | mwe.co.uk World leaders in pre-analytics MWE proudly supports

RACE STATISTICS PLAY SMARTER 20 FOURTH RACE 6.20PM 6fTHE SUPPORTINGMWE JULIA’S HOUSE HANDICAP STAKES (CLASS 6) for three yrs old x Total race value £7250 x Race Conditions P31 Owners Prize Money. 1st £2838, 2nd £1418, 3rd £710, 4th £354, 5th £240, 6th £240. (Penalty Value £3590.99) 1-2-3: 1.WHISTLEDOWN 2.BRAZEN IDOL 3.THANK THE LORD colours no horse/days since last run st-lb Draw 1 SOCIAL CONTACT (GB) (25) 9-9 (5) Breeding Ch f Night of Thunder (IRE) - Operettist (Singspiel (IRE)) Jockey Tom Marquand Owner Longview Stud & Bloodstock Ltd Trainer Tony Carroll, Cropthorne Breeder Longview Stud & Bloodstock Ltd Timeform Rating HHHII Form 006535 TIMEFORM 11/2, last of 5 in handicap at Windsor (6f, firm) 25 days ago. BHA 65 2 WHISTLEDOWN (GB) (10) 9-9 (4) Breeding Gr f Gregorian (IRE) - El Che (Winker Watson) Jockey George Bass (3) Owner Norman Court Stud & Partner Trainer Mick Channon, West Ilsley Breeder P Taplin & Mike Channon Bloodstock Ltd Timeform Rating HHHHH Form 651222 D TIMEFORM Latest win at Epsom in July. Good second of 8 in handicap (3/1) at Epsom (7f, good to firm) 10 days ago, just failing. Shortlist material. BHA 65 (+1) 3 BRAZEN IDOL (GB) (35) 9-4 (3) Breeding Br g Brazen Beau (AUS) - Babylon Lane (Lethal Force (IRE)) Jockey Charles Bishop Owner The Infinite Folly Partnership Trainer Simon Pearce, Newmarket Breeder Rosyground Stud Timeform Rating HHHHI Sponsor Tattersalls Form 414211 D TIMEFORM 3 wins from 6 runs this year. 11/8, career best when winning 13-runner handicap at Thirsk (6f, good) 35 days ago. Can give another good account. BHA 60 4 HINES (GB) (111) 9-3 (9) Breeding Ch g Spill The Beans (AUS) - Synaesthesia (FR) (High Chaparral (IRE)) Jockey Joey Haynes Owner Endless Acres ten Trainer Adam West, Epsom Breeder Mr Anthony Morris Timeform Rating HHHII Form 000-5 TIMEFORM Lightly-raced maiden. Respectable fifth of 11 in handicap at Lingfield (7.6f, good to firm, 16/1). Off 111 days. Down in trip. Something to find on form. BHA 59 5 ROMANTIC MEMORIES (GB) (33) 9-1 (8) Breeding B f Time Test - Midnight Fling (Groom Dancer (USA)) Jockey Hector Crouch Owner Mr S. Emmet and Miss R. Emmet Trainer Jonathan Portman, Upper Lambourn Breeder Mr S. Emmet and Miss R. Emmet Timeform Rating HHIII Sponsor Pump Technology Limited Form 0-00205 TIMEFORM Fifth of 7 in handicap (20/1) at Windsor (6f, good to firm) 33 days ago. BHA 57 6 JUANITA (GB) (32) 8-11 (1) Breeding B f Adaay (IRE) - Kip (Rip Van Winkle (IRE)) Jockey Cieren Fallon Owner Ms Aoife Dunphy Trainer Denis Coakley, West Ilsley Breeder Little Park Farm Timeform Rating HHHII Sponsor Denis Coakley Racing Form 66-6563 TIMEFORM Good third of 10 in handicap at Windsor (6f, good to firm, 4/1) 32 days ago. BHA 53 7 THANK THE LORD (GB) (19) 8-6 (6) Breeding Ch g Coach House (IRE) - Lady Phill (Avonbridge) Jockey Theodore Ladd Owner Mrs M. S. Teversham Trainer Simon Hodgson, Hook Breeder Mrs Monica Teversham Timeform Rating HHHHI Form 500103 C TIMEFORM Course winner. Winner here in July. Cheekpieces on for 1st time, creditable third of 6 in handicap (13/2) at Yarmouth (6f, good to firm) 19 days ago. Blinkers on 1st time. Looks competitive on form. BHA 48 Leading course trainer (17-22): M Channon (14 wins from 108 runners, 13%) runs WHISTLEDOWN Trainer-in-form (last 14 days): T Carroll (3 wins from 32 runners, 9%) runs GO POPPY and SOCIAL CONTACT Longest Traveller: BRAZEN IDOL trained by S Pearce, Newmarket, 151 miles.

RACEFOURTH 21 8 TILSWORTH JADE (GB) (19) 8-4 (2) Breeding B f Ardad (IRE) - Ashwell Rose (Anabaa (USA)) Jockey Tyler Heard (3) Owner Mr M. Ng Trainer J. R. Jenkins, Royston Breeder Michael Ng Timeform Rating HHIII Sponsor Tilsworth Stud Farm Form 0-00054 TIMEFORM 150/1, fourth of 6 in handicap at Yarmouth (6f, good to firm) 19 days ago. Others more persuasive. BHA 42 9 GO POPPY (GB) (22) 8-4 (7) Breeding Ch f Coach House (IRE) - By Rights (Byron) Jockey Mollie Phillips (5) Owner Mayden Stud Trainer Tony Carroll, Cropthorne Breeder Mayden Stud Timeform Rating HHHII Sponsor Mayden Stud Form 00665 TIMEFORM Lightly-raced maiden. Good fifth of 15 in handicap (50/1) at Chepstow (6.1f, good to firm) 22 days ago. BHA 42 DECLARED RUNNERS 9 2021: ROOFUL 3 8 1 Georgia Dobie 12-1 (Eve Johnson Houghton) 10 ran Raceform Median Time: 1 min 16.50 secs Blinkers worn first time by No. 7. Hood worn by No. 6. Betting Forecast: 5-2 Brazen Idol (GB), 7-2 Whistledown (GB), 6-1 Juanita (GB), 8-1 Thank The Lord (GB), 17-2 Social Contact (GB), 20-1 Hines (GB), 22-1 Tilsworth Jade (GB), 28-1 Go Poppy (GB), 33-1 Romantic Memories (GB) Race Summary: WHISTLEDOWN arrives in top form, only just failing at Epsom 10 days ago, and can resume winning ways off the same mark back down in trip. Brazen Idol is bidding for the hat-trick and is feared most ahead of Thank The Lord. FREE form for all British and Irish meetings is available online every day at timeform.com/free PLAY SMARTER 1ST 2ND 3RD 4TH Proudly supports PA CE Y OU RS EL F AL LO W ON E S OF T D RI NK B ET WE EN EV ER Y AL CO HO LI C DR IN K UNAUTHORISED BOOKMAKING It is a condition of entry to this Racecourse that only individuals in possession of a valid betting badge and occupying an authorised pitch are entitled to lay bets on the course of their business. Any individual found contravening these conditions will be evicted. APPROXIMATE ODDS Odds Indicator Boards are now all marked Approximate Odds and all show the same approximate odds on offer at any given time before the start. It will be appreciated that these are intended as a guide and cannot necessarily reflect the resultant S.P. or the Tote Dividend of the winner.







Silent
Lot 3: 4 x Director’s Box tickets to Newcastle v Bournemouth, St James’ Park on 17th September 2022 – Donated by Julia’s House Patron, Eddie Howe Lot 4: AFC Bournemouth Signed Shirt – Donated by MSP Capital Lot 5: Electric Mountain Bike Experience for two – Donated by Cranks and Planks with picnic donated by the Fonthill Estate Lot 6: Signed Swindon Town FC Shirt – Donated by Imagine Cruising Lot 7: Directors Box tickets for Newcastle v Chelsea at St James’ Park for 4 people – Donated by Julia’s House Patron Eddie Howe Lot 8: Gozney Roccbox Pizza Oven – Donated by Gozney Lot 9: A Round of Golf for Four at Cumberwell Park Golf Club – Donated by Cumberwell Park Golf Club Lot 10: A Rustic Country Getaway in Devon – Donated by Wilfred EmmanuelJones, The Black Farmer Lot 11: Golden Boot In Case Signed by Sir Geoff Hurst – Donated by A1 Memorabilia Lot 12: Omlet Topology Dog Bed – Donated by Omlet Lot 13: Farrow & Ball Interior Design Consultancy with Design Book – Donated by Farrow & Ball Lot 14: Framed Newcastle FC Shirt Signed by 2022 Team – Donated by Newcastle FC Lot 15: Symphonic Queen at the Royal Albert Hall for two – Donated by Imagine Cruising Lot 16: L’Occitane Indulgence Hamper – Donated by L’Occitane Lot 17: Helicopter Sightseeing Tour of Dorset’s South Coast – Donated by Bliss Aviation Lot 18: Framed and Signed Pele Shirt – Donated by A1 Memorabilia
Get your hands on these fantastic prizes all while supporting local children with life-limiting and life-shortening conditions
Lot 1: 2023 Bahrain Grand Prix Weekend Experience including flights, hotel and McLaren Garage Tour! – Donated by Anonymous Lot 2: Be in a Guy Ritchie movie! – Donated by Julia’s House Patron, Guy Ritchie
Lot 22: A Private Tour of Arundells Grade II Listed Building – Donated by Arundells
Lot 19: Novara Dining Table and Chair Set - Donated by Monty and Dan from FurnitureboxUK Lot 20: A Round of Golf at Broadstone Golf Club, Dorset – Donated by Broadstone Golf Club Lot 21: Lunch for Two at the Pythouse Kitchen Garden, Tisbury – Donated by Pythouse Kitchen Garden
Auction
Lot 23: Signed Children’s Cook Book by Annabel Karmel – Donated by Julia’s House Patron, Annabel Karmel Lot 24: Hotel Stay for Two at The Eastbury Hotel – Donated by Peter DeSavory, The Eastbury Hotel Lot 25: Framed and Signed Matt Le Tissier Photo – Donated by A1 Memorabilia Lot 26: Hotel Stay at the Grosvenor Hotel, Stockbridge – Donated by the Grosvenor Hotel Lot 27: Seychelles Indulgence Gift Set from The White Company – Donated by Lucinda Lloyd, Jane James and Associates Lot 28: Mid-week Hotel Break at the Kings Head Hotel in Cirencester – Donated by Kings Head Hotel, Cirencester Lot 29: Hotel Stay for Two in Lyme Regis – Donated by Kathryn Haskins, Director, Alexandra Hotel and Restaurant Lot 30: Evening Tour at the Ramsbury Brewery and Distillery – Donated by Ramsbury Brewing & Distilling Co. Ltd Lot 31: Signed Martin Johnson Photo, 2003 World Cup – Donated by Anonymous Lot 32: Round of golf for four people including full English breakfast and Range Balls – Donated by Remedy Oak Golf Club Lot 33: Family Lesson at Snowtrax Alpine Activity Centre – Donated by Snowtrax Lot 34: Beautiful Row of Freshwater Pearls – Donated by HR Tribbecks & Son Lot 35: Hotel Stay and Dinner at the Falkland Arms – Donated by Wadworth & Co Ltd Lot 36: Perfume Making Workshop – Donated by Keyneston Mill Lot 37: Wine Tour and Tasting in Salisbury – Donated by Bluestone Vineyards Lot 38: Escape Room Experience – Donated by Live Escape Salisbury Lot 39: TV, Soundbar and Printer Bundle – Donated by Tesco Simply scan the QR code below to view the auction site and start bidding! Or go www.jumblebee.co.uk/auction/detail/auction_id/6929to:1.
2. Click on the red Sign In/Register button at the top right hand of the screen. 3. Click on an item to view the image and the description. 4. Enter your bid amount and Bid Now. Good luck!
6. To check the status of your bids, go to Account Settings, My Bids.
5. You will receive an onscreen message to confirm your bid which will also display on the leaderboard. You will receive a confirmation email of your bid and an email notification when you are outbid.
On your device either scan the QR code or go to the URL above.








RACE STATISTICS PLAY SMARTER 25 FIFTH RACE 6.50PM 1m 6f 44yTHE WEATHERBYS BLOODSTOCK PRO PERSIAN PUNCH CONDITIONS STAKES (CLASS 2) (GBB RACE) for three yrs old and upwards x Total race value £22500 x Race Conditions P31 Owners Prize Money. 1st £9142, 2nd £4572, 3rd £2286, 4th £1143. (Penalty Value £11596.50) 1-2-3: 1.RANCH HAND 2.DILLIAN (IRE) 3.GLOBAL HEAT (IRE) colours no horse/days since last run age st-lb Draw 1 GLOBAL HEAT (IRE) (55) 6 9-7 Breeding B g Toronado (IRE) - Raskutani (Dansili) Jockey Tom Marquand Owner Godolphin Trainer Saeed bin Suroor, Newmarket Breeder Wellsummers Farm Timeform Rating HHHHI Sponsor Emirates Fly Better Form 353532 TIMEFORM Fifteen runs since last win in 2021. Tongue strap on for 1st time, good second of 7 in handicap at Ripon (12f, good to firm, 10/3) 55 days ago. Blinkers on 1st time. BHA 100 2 RANCH HAND (GB) (454) 6 9-7 Breeding B g Dunaden (FR) - Victoria Montoya (High Chaparral (IRE)) Jockey William Carver Owner Kingsclere Racing Club Trainer Andrew Balding, Kingsclere Breeder Kingsclere Stud Timeform Rating HHHHH Sponsor Kingsclere Stud Form 1/11424- D TIMEFORM Smart gelding. Six wins from 17 Flat runs. 3 1/4 lengths last of 4 to Roberto Escobarr in listed race at York (13.8f, good to firm, 16/5). Off 15 months. Can make a successful return. BHA 105 3 RUNRIZED (FR) (90) 7 9-7 Breeding B g Authorized (IRE) - Courseulles (FR) (Monsun (GER)) Jockey Joey Haynes Owner Crowd Racing Partnership Trainer Camilla Poulton, Lewes Breeder S.C.E.A. Ecurie Cerdeval Timeform Rating HIIII Sponsor Gold & Green Crowd Form 15///60-00 TIMEFORM Fairly useful performer at 3 yrs, lightly raced on Flat since, failing to beat a rival in handicaps both starts in 2022. Engaged 14.15 Epsom Thursday. BHA 67 4 DILLIAN (IRE) (321) 3 8-12 Breeding B c Camelot - Debdebdeb (Teofilo (IRE)) Jockey Dylan Hogan Owner Mr Dermot Hanafin Trainer Michael Bell, Newmarket Breeder Dermot Hanafin Timeform Rating HHHHI Sponsor M.I.S. Motorsport Form 416TIMEFORM Useful colt. 25/1, 3 3/4 lengths sixth of 9 to El Bodegon in Criterium de Saint-Cloud at Saint-Cloud (9.9f, soft). Off 10 months. Significantly up in trip which will suit and he could go well on return. BHA 103

RACEFIFTH Leading
Longest
The Great British Bonus (GBB) offers multiple bonuses of up to £20,000 per eligible race for British-bred fillies and mares.
PLAY SMARTER 1ST
Trainer-in-form
DECLARED RUNNERS 4 2021: QUICKTHORN 4 9 9 Cieren Fallon 7-4 (Hughie Morrison) 4 ran Raceform Median Time: 3 mins 8.00 secs Blinkers worn first time by No. 1. Tongue Strap worn by No. 1, 3. Betting Forecast: 7-4 Global Heat (IRE), 2-1 Ranch Hand (GB), 9-4 Dillian (IRE), 150-1 Runrized (FR) Race Summary: RANCH HAND has been off the track for 15 months but he’s a smart performer at his best so is taken to defy the absence. Dillian is another returning from a long lay-off but he showed useful form as juvenile and should make a better 3-y-o at this sort of trip, so rates the main threat. FREE form for all British and Irish meetings is available online every day at timeform.com/free 2ND 3RD 4TH course trainer (17-22): A Balding (24 wins from 171 runners, 14%) runs RANCH HAND (last 14 days): A Balding (6 wins from 52 runners, 12%) runs RANCH HAND Travellers: DILLIAN trained by M Bell & GLOBAL HEAT trained by S bin Suroor, both Newmarket, 151 miles.
GREAT BRITISH BONUS SCHEME




Symonds Event Catering is a family run event catering business for over 40 years, which has always been based in Salisbury. We have had the privilege for the last eleven seasons of supplying Salisbury Racecourse with a catering service, we hope you can enjoy and be proud of. Symonds Event Catering are delighted to sponsor The Symonds Event Catering British EBF Novice Stakes and wish all racegoers an enjoyable evening. Contact details: Peter Symonds Symonds Event Catering The petersymonds25@yahoo.co.ukSouthamptonDormersRoadSalisburySP53DB

SYMONDSCATERINGEVENT
RACE STATISTICS PLAY SMARTER 28 SIXTH RACE 7.20PM 1m 1f 201yTHE SYMONDS EVENT CATERING BRITISH EBF NOVICE STAKES (CLASS 4) (GBB RACE) for novice three yrs old and upwards x Total race value £10000 x Race Conditions P31 Owners Prize Money. 1st £4267, 2nd £2133, 3rd £1067, 4th £533. (Penalty Value £5400) 1-2-3: 1.WESSALL 2.CHANTICO 3.MELFET (IRE) colours no horse/days since last run age st-lb Draw 1 NOBEL (IRE) (275) 3 9-11 (8) Breeding Ch c Lope de Vega (IRE) - Starlet (IRE) (Sea The Stars (IRE)) Jockey Cieren Fallon Owner Qatar Racing Limited Trainer Andrew Balding, Kingsclere Breeder Lord Halifax Timeform Rating HHHII Sponsor Tweenhills Farm & Stud Ltd Form 1TIMEFORM Won 10-runner minor event at Kempton (8f, 3/1) on debut, well on top finish. Off 9 months. Up in trip. Open to improvement. BHA2 HALF NELSON (GB) (45) 7 9-10 (1) Breeding Ch g Mount Nelson - Maria Antonia (IRE) (King’s Best (USA)) Jockey Kieran O’Neill Owner Jonathan Thomas & Partner Trainer Grace Harris, Shirenewton Breeder Clear Racing Ltd Timeform Rating HHIII Sponsor Grace Harris Racing Form TIMEFORM Tongue strap on for 1st time, last of 9 in handicap hurdle at Worcester (16f, good, 80/1) 45 days ago. More needed. BHA3 MIDNIGHT SHIMMER (GB) (15) 4 9-10 (3) Breeding Gr g Dream Eater (IRE) - Midnight Sequel (Midnight Legend) Jockey Elisha Whittington (5) Owner Dajam Ltd Trainer Neil Mulholland, Limpley Stoke Breeder Mike Burbidge Timeform Rating HHIII Form 0 TIMEFORM Once-raced maiden. 150/1, ninth of 10 in minor event at Ffos Las (12f, good to soft) on debut 15 days ago. BHA4 BYKER (IRE) (42) 3 9-4 (5) Breeding B g Le Havre (IRE) - Bridge of Peace (Anabaa (USA)) Jockey Sean Levey Owner Mr Michael Pescod Trainer Richard Hannon, Marlborough Breeder Clive Washbourn Timeform Rating HHHII Sponsor Chibley Farm Partnership Form 56 TIMEFORM Twice-raced maiden. 11/2, sixth of 10 in minor event at Southwell (11.1f) 42 days ago. Gelded after. Open to progress. BHA5 CHANTICO (GB) (-) 3 9-4 (7) Breeding B g Kingman - Deuce Again (Dubawi (IRE)) Jockey Jefferson Smith Owner KHK Racing Trainer Roger Varian, Newmarket Breeder Meon Valley Stud Timeform Rating HHHHI Sponsor Oliver St Lawrence Bloodstock Limited Form TIMEFORM 100,000 gns yearling, Kingman gelding. Dam, 11f-1 3/4m winner, half-sister to useful 1 1/2m winner (stayed 15.5f) Return Ace. Makes plenty of appeal on paper. One to note. BHA6 FIRTH OF CLYDE (IRE) (347) 3 9-4 (4) Breeding B g Gleneagles (IRE) - Chrysanthemum (IRE) (Danehill Dancer (IRE)) Jockey Charles Bishop Owner Mrs Fitri Hay Trainer Paul & Oliver Cole, Whatcombe Breeder Barnane Stud Ltd Timeform Rating HHHII Sponsor JMH Group Form 42222TIMEFORM Lightly-raced maiden. Good second of 8 in minor event at Bath (8f, good, 8/13). Off 11 months (also gelded) so needs to hit the ground running. BHA 83 7 MELFET (IRE) (268) 3 9-4 (6) Breeding B c Shalaa (IRE) - Al Jassasiyah (IRE) (Galileo (IRE)) Jockey Martin Harley Owner Al Shaqab Racing Trainer John & Thady Gosden, Newmarket Breeder Al Shaqab Racing Timeform Rating HHHHI Sponsor Haras De Bouquetot Form 5TIMEFORM Promising type. Fifth of 10 in maiden (12/1) at Kempton (8f) on debut, nearest finish. Off 8 months. Up in trip and remains with potential. BHALeading course trainer (17-22): R Hannon (31 wins from 331 runners, 9%) runs BYKER Trainer-in-form (last 14 days): R Varian (13 wins from 40 runners, 32%) runs CHANTICO Longest Travellers: WESSALL trained by W Haggas, MELFET trained by J & T Gosden & CHANTICO trained by R Varian, all Newmarket, 151 miles.

Race Summary: WESSALL showed the benefit of a wind op when runner-up at Kempton and with that form having been franked he is taken to progress again and open his account. Roger Varian’s newcomer Chantico appeals on pedigree and is feared most with the returning Melfet another who needs considering. FREE form for all British and Irish meetings is available online every day at timeform.com/free
REGAL RAMBLER: Following its run on 25/8/2022 it was reported that the horse hung right handed late-on. Betting Forecast: 7-2 Regal Rambler (IRE), 5-1 Firth of Clyde (IRE), 11-2 Nobel (IRE), 6-1 Chantico (GB), 15-2 Melfet (IRE), Wessall (GB), 9-1 Byker (IRE), 100-1 Dulcet Spirit (GB), 250-1 Half Nelson (GB), Midnight Shimmer (GB)

PLAY SMARTER 1ST 2ND 3RD 4TH WELFARE INTEGRITY EQUALITY SAFEGUARDING WELFARE INTEGRITY QUALITY SAFEGUARDING If you have concerns about the integrity of British racing or the wellbeing of the sport’s participants, human or equine, please contact RaceWISE. Anonymous reporting. Call 08000 852 580 (free 24 hours a day) Visit britishhorseracing.com/RaceWISE GREAT BRITISH BONUS SCHEME The Great British Bonus (GBB) offers multiple bonuses of up to £20,000 per eligible race for British-bred fillies and mares.

RACESIXTH 29 8 REGAL RAMBLER (IRE) (15) 3 9-4 (2) Breeding B g Dark Angel (IRE) - Rural Celebration (Pastoral Pursuits) Jockey Thomas Greatrex Owner Mr B. J. Meehan Trainer Brian Meehan, Manton Breeder Grangemore Stud Timeform Rating HHHII Sponsor Sirecam Europe Form 52 TIMEFORM Twice-raced maiden. Second of 10 in maiden (13/2) at Chelmsford City (8f) 15 days ago, having run of race. Up in trip. Considered. BHA9 WESSALL (GB) (24) 3 9-4 (9) Breeding Gr g Dark Angel (IRE) - Alwarga (USA) (Street Sense (USA)) Jockey Tom Marquand Owner Sheikh Ahmed Al Maktoum Trainer William Haggas, Newmarket Breeder Godolphin Timeform Rating HHHHH Form 02 TIMEFORM Had wind op and tongue tied, good second of 12 in minor event at Kempton (8f, 7/2) 24 days ago, well positioned. Up in trip. Should improve further. Player. BHA10 DULCET SPIRIT (GB) (473) 3 8-13 (10) Breeding B f Invincible Spirit (IRE) - Dulcet (IRE) (Halling (USA)) Jockey Nicola Currie Owner The Alvediston Stud Partnership Trainer Marcus Tregoning, Whitsbury Breeder Rabbah Bloodstock Limited Timeform Rating HHIII Sponsor Alvediston Stud Limited Form 0TIMEFORM Last of 10 in minor event (25/1) at Wolverhampton (6.1f) on debut. Off 15 months. Significantly up in trip. First run for yard after leaving James Tate with more required. BHADECLARED RUNNERS 10 2021: SAYF AL DAWLA 3 9 1 Jason Watson 13-8 (Peter Chapple-Hyam) 7 ran Raceform Median Time: 2 mins 9.30 secs Tongue Strap worn by No. 2, 9. Running for the first time since Gelding No. 4, 6. Stewards MIDNIGHTNote:SHIMMER: Following its run on 25/8/2022 it was reported that the horse lost a shoe.
FIRTH OF CLYDE: Following its run on 27/9/2021 it was reported that the horse hung right handed off the bend. MELFET: Following its run on 15/12/2021 it was reported that the horse was slowly away.


T: +44 1638 665931 sales@tattersalls.com www.tattersalls.com NATIVE TRAIL IRISH 2000 GUINEAS, CHAMPION 2YO purchased at TATTERSALLS OCTOBER YEARLING SALE, BOOK 1 for 67,000 gns purchased at TATTERSALLS CRAVEN BREEZE UP SALE for 210,000 gns THECROWNDESERTDERBY purchased at TATTERSALLS OCTOBER YEARLING SALE, BOOK 2 for 280,000 gns 1000CACHETGUINEAS purchased at TATTERSALLS CRAVEN BREEZE UP SALE for 60,000 gns Europe’s Premier source of Classic Winners















RACE CONDITIONS
First Race 4.50 - THE NUCLEUS FINANCIAL SUPPORTING JULIA’S HOUSE RESTRICTED NOVICE STAKES (CLASS 4) (for horses in Bands B, C and D) (GBB RACE) Distributed in accordance with the Stakes and Prize Money Code. £4860 to the winning horse The second to receive £2281, the third £1141 and the fourth £570. for novice two yrs old, which are in Bands B, C and D. Enter by noon, September 3rd and pay £25 stake, Declare by 10.00 a.m. September 7th. Weights: Colts and geldings 9st 4lb; fillies 8st 13lb Penalties, for each race won 7lb (Sellers and Claimers excluded for the purposes of penalties) Allowances: Band C from Band B 2lb Band D from Band C 2lb (Allowances are cumulative). Nucleus Financial has kindly sponsored this race. They will present a memento to the winning owner and provide £50 for the best turned out horse. 19 entries at £25. - Closed September 3rd, 2022. Owners Prize Money. Winner £3840; Second £1920; Third £960; Fourth £480. (Penalty Value £4860) Weights raised 3lb and paragraphs 27 to 31 of the Weights and Handicapping Code complied with where applicable. SS SEE PAGE 8 FOR THIS RACE.
SS SEE PAGE 17 FOR THIS RACE. Fourth Race 6.20 - THE MWE SUPPORTING JULIA’S HOUSE HANDICAP STAKES (CLASS 6) Distributed in accordance with the Stakes and Prize Money Code. £3590 to the winning horse The second to receive £1685, the third £843, the fourth £421, the fifth £300 and the sixth £300. for three yrs old only, Rated 46-65 (also open to such horses rated 66 and 67; such horses rated 45 and below are also eligible - see Standard Conditions). £24 stake if the horse is rated 46 or higher, or £4 stake if the horse is rated 45 or lower with £20 extra if the horse is declared to run Declare by 10.00 a.m. September 7th. Lowest weight 8st 4lb; Highest weight 9st 9lb Penalties, after August 27th, 2022, for each race won 6lb. MWE has kindly sponsored this race. They will present a memento to the winning owner and £50 will be provided for the best turned out horse. 16 entries, 1 at £4 and 15 at £24. - Closed September 3rd, 2022. Owners Prize Money. Winner £2838; Second £1418; Third £710; Fourth £354; Fifth £240; Sixth £240. (Penalty Value £3590.99) SS SEE PAGE 20 FOR THIS RACE.
Fifth Race 6.50 - THE WEATHERBYS BLOODSTOCK PRO PERSIAN PUNCH CONDITIONS STAKES (CLASS 2) (GBB RACE) Distributed in accordance with the Stakes and Prize Money Code. £11596 to the winning horse The second to receive £5438, the third £2720 and the fourth £1359. for three yrs old and upwards, which have not won a Pattern race in 2022. Enter by noon, September 3rd and pay £85 stake, Declare by 10.00 a.m. September 7th. Weights: 3-y-o colts and geldings 8st 12lb; fillies 8st 7lb 4-y-o and up colts and geldings 9st 7lb; fillies 9st 2lb Penalties, after 2021, a winner of a Class 2 race 4lb Of a Listed race 7lb Note: Excluding the winner, the Official BHA Rating of any horse taking part in this race will not be increased due to performance in this race, providing the horse has had at least four prior completed runs. Weatherbys has kindly sponsored this race. They will present a memento to the winning owner and provide £50 for the best turned out horse. The British Horseracing Authority has given permission for this race to be started with a Flip-Start starting gate. 10 entries at £85. - Closed September 3rd, 2022. Owners Prize Money. Winner £9142; Second £4572; Third £2286; Fourth £1143. (Penalty Value £11596.50) A SEE PAGE 25 FOR THIS RACE.
Sixth Race 7.20 - THE SYMONDS EVENT CATERING BRITISH EBF NOVICE STAKES (CLASS 4) (GBB RACE) Distributed in accordance with the Stakes and Prize Money Code. £5400 to the winning horse The second to receive £2535, the third £1268 and the fourth £634. for novice three yrs old and upwards, which are E.B.F. eligible. Enter by noon, September 3rd and pay £38 stake, Declare by 10.00 a.m. September 7th. Weights: 3-y-o colts and geldings 9st 4lb; fillies 8st 13lb 4-y-o and up colts and geldings 9st 10lb; fillies 9st 5lb Penalties, for each Restricted Novice or Maiden race won 5lb For each other race won 7lb (Where appropriate, median auction and auction Novice or Maiden races will carry the same penalty as Restricted races) (Sellers and Claimers excluded for the purposes of penalties). Symonds Event Catering has kindly sponsored this race. They will present a memento to the winning owner and provide £50 for the best turned out horse. THE TRUSTEES OF THE E.B.F. have kindly contributed £1000 towards the prize money for this race. 28 entries at £38. - Closed September 3rd, 2022. Owners Prize Money. Winner £4267; Second £2133; Third £1067; Fourth £533. (Penalty Value £5400) SS SEE PAGE 28 FOR THIS RACE. 31
Second Race 5.20 - THE IMAGINE CRUISING SUPPORTING JULIA’S HOUSE NURSERY HANDICAP STAKES (CLASS 5) Distributed in accordance with the Stakes and Prize Money Code. £4266 to the winning horse The second to receive £2002, the third £1001, the fourth £500, the fifth £300 and the sixth £300. for two yrs old only, Rated 0-75 (also open to such horses rated 76 and 77 - see Standard Conditions). Enter by noon, September 3rd and pay £28 stake, Declare by 10.00 a.m. September 7th. Lowest weight 8st 2lb; Highest weight not less than 9st 9lb Penalties, after August 27th, 2022, for each race won 6lb. Imagine Cruising has kindly sponsored this race. The winning owner will receive a memento and £50 will be provided for the best turned out horse. 14 entries at £28. - Closed September 3rd, 2022. Owners Prize Money. Winner £3371; Second £1685; Third £843; Fourth £421; Fifth £240; Sixth £240. (Penalty Value £4266) SS SEE PAGE 12 FOR THIS RACE. Third Race 5.50 - THE IRISH STALLION FARMS EBF ARCHIE FORD 18TH BIRTHDAY FILLIES’ NURSERY HANDICAP STAKES (CLASS 3) Distributed in accordance with the Stakes and Prize Money Code. £8100 to the winning horse The second to receive £3802, the third £1902 and the fourth £951. for two yrs old fillies only, which are E.B.F. eligible, Rated 0-90 (also open to such horses rated 91 and 92 - see Standard Conditions). Enter by noon, September 3rd and pay £65 stake, Declare by 10.00 a.m. September 7th. Lowest weight 8st 2lb; Highest weight not less than 9st 9lb Penalties, after August 27th, 2022, for each race won 6lb. THE GOVERNORS OF THE IRISH E.B.F. have kindly contributed £5000 towards the prize money for this race. The family of Archie Ford have also sponsored this race. A memento will be presented to the winning owner and £50 will be provided for the best turned out horse. 13 entries at £65. - Closed September 3rd, 2022. Owners Prize Money. Winner £6401; Second £3200; Third £1601; Fourth £800. (Penalty Value £8100) Weights raised 6lb and paragraphs 27 to 31 of the Weights and Handicapping Code complied with where applicable.
To book tickets and for more details visit salisburyracecourse.co.uk 2022 Thursday 29th September 2023 Thursday 4th May Sunday 7th May Thursday 18th May Saturday (eve) 27th May Tuesday 13th June Sunday 18th June Wednesday 28th June Saturday (eve) 15th July Saturday (eve) 29th July Thursday (eve) 10th August Wednesday 16th August Thursday 17th August Friday (eve) 1st September Thursday 7th September Friday (eve) 15th September Thursday 5th October 20222023& FIXTURES






